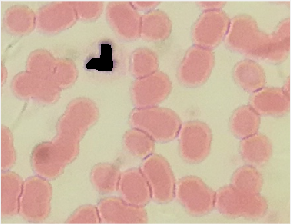

血液红细胞识别与计数系统的设计与实现毕业论文
2020-04-10 16:55:47
摘 要
近些年来,图像处理(Image Processing)技术已经广泛应用到生产的各个领域和人们的日常生活中,如工业、医药业、电子设备、通讯、智能家电等应用方向。在医学中,血液细胞检测是一项重要内容,但现阶段所采用的方法仍有一定误差。图像识别是图像处理的一个重要内容,在医学领域中也起着十分重要的作用。
在本次设计中,主要运用图像处理中的连通域算法,分水岭算法还有根据细胞图像特点设计的面积算法。本文的主要研究内容如下:
(1)明确细胞识别计数的目的及意义,阅读参考文献了解细胞识别技术的国内外发展及研究现状。对血液原始细胞图像进行初步处理,分析红细胞图像以及白细胞图像所携带的特征,为后续处理做准备。
(2)对预处理结果进行形态学处理,分离出白细胞和红细胞,可以更加方便的对白细胞和红细胞进行计数处理。
(3)对分离出的白细胞和红细胞细胞图像进行细胞计数,分析各种算法计数的准确性,并且选择最合适的算法应用与系统中。
(4)基于MATLAB平台设计一个血液细胞识别计数系统,采用连通域算法,面积法,分水岭算法对细胞图像进行细胞进行识别计数处理,将计数结果进行比较分析,进一步阐述这几种算法的特点和优劣势。
关键词:细胞计数;特征提取;细胞识别;图像分割;分水岭算法
Abstract
In recent years, Image Processing technology has been widely applied to various fields of production and people's daily life, such as industrial, pharmaceutical, electronic equipment, communications, smart appliances and other applications. In medicine, blood cell detection is an important part, but there are still some errors in the methods used at this stage. Image recognition is an important part of image processing and plays a very important role in the medical field.
This paper mainly uses the algorithms of image processing to perform the realization of the cell recognition counting system. The main work of this article is as follow:
(1) To be sure purpose and meaning of the cell recognition count and to realize the development and research status of cell recognition technology by reading relative document literature. Pretreating the image of blood cell and analyzing white cells and red blood cells.
(2) Treat the results of the pretreatment by morphological methods, and then isolating the white blood cells and red blood cells.
(3) Counting the isolated cells in the image and then analyzing the influence of using connected domain algorithm and watershed algorithm on the counting results.
(4) To design a simple cell recognition counting system by using MATLAB platform. Using the connected domain algorithm, area algorithm and watershed algorithm to recognize and count cells. Then comparing and analyzing the counting results and further expounds the characteristics and disadvantages of these two kinds of algorithm.
Keywords: cell counting; feature extraction; cell identification; image segmentation; watershed algorithm
目 录
摘 要 I
Abstract II
第1章 绪 论 1
1.1课题研究的目的及意义 1
1.2国内外发展与研究现状 2
1.3本文研究的主要内容 3
第2章 系统总体设计和关键技术分析 4
2.1计数系统总体设计 4
2.1.1 需求分析 4
2.1.2 功能模块设计 4
2.2关键技术分析 5
2.2.1 血液细胞特征提取 5
2.2.2 计数算法分析 6
2.3本章小结 8
第3章 血液细胞图像预处理实现 9
3.1白细胞图像提取处理 9
3.1.1 分离空间分量 9
3.1.2 K均值聚类算法设计 11
3.1.3 形态学处理 13
3.2红细胞图像提取处理 15
3.2.1 还原彩色图像 15
3.2.2 分离空间分量 16
3.2.3 细胞区域分割 16
3.2.4 形态学处理 18
3.3本章小结 18
第4章 细胞计数实现 19
4.1白细胞计数 19
4.1.1 基于连通域的计数方法 19
4.1.2 基于分水岭算法的计数方法 20
4.2红细胞计数 22
4.2.1 基于面积的计数方法 22
4.2.2 基于分水岭算法的计数方法 24
4.3本章小结 26
第5章 细胞计数系统设计及仿真 27
5.1血液细胞识别计数系统设计 27
5.2系统测试与评价 30
5.3本章小结 31
第6章 总结与展望 32
6.1论文工作总结 32
6.2未来工作展望 33
参考文献 34
致 谢 35
第1章 绪 论
1.1课题研究的目的及意义
在医学中,红细胞的数量是诊断许多疾病的重要指标之一[1]。因此,红细胞计数的分析是血检的一项重要内容,也是医生诊断病人的重要依据。
最开始的血液检测都是在显微镜下完成的,显微镜有很大的局限性。首先,将血液利用玻片制作成血液涂片,再从显微镜中观察细胞形态,个数等相关的参数。整个检测过程全部由人工完成,所以非常耗时,并且精度无法保证[2]。
后来有了血球计数板,可以利用血球计数板进行浓度估计,但这种估算方法会将部分杂质和没有活性的细胞也当做活细胞计算在内,有一定的误差。
现如今血液检测技术不断提高。例如,普通血液分析仪已经广泛应用于医学临床检查。血细胞分析仪使用电阻抗和/或光散射原理[3]。由于血细胞与稀释剂相比是比较差的导体,当血液流经微孔时,挤压等量的稀释剂在电路上形成短路电阻,导致电压变化,电压变化产生相应的脉冲信号,放大后加入,进行识别和记录。将脉冲数转换成单元数;经计算机处理后,根据处理结果可以得出各种相关参数。由于电阻式血细胞分析仪操作简便、快速、分析参数多、价格低廉,在我国得到了广泛的应用[4]。但是,如今这种分析仪已经被更新,数字化的仪器更加受欢迎。
但是血液自动分析仪这样的高科技医疗仪器并不能很好地区分血细胞的形态和结构,目前只作为血液细胞分析的筛选方法。在遇见疑问的情况下,还必须在显微镜下检查血膜,经过确认、修改或补充,出具一份报告,否则,容易造成误诊[5][6]。在对标准的审查中,现有的医学测试教材和操作程序没有明确的讨论。自动血液分析仪如果有异常结果,则需要重新进行显微镜检查。为了便于图像的存储和传输,可以对图像数据进行一些操作,例如图像的变换、编码和压缩等方法[7][8]。数字化在未来一定会成为主流技术,使人们的生活越来越方便与快捷。
生物细胞图像自动识别的技术对医学研究人员有着非常大的帮助,尤其是在细胞疾病诊断,细胞信息研究以及细胞的变异研究都起着非常重要的作用。图像处理在各个领域都有重要的作用。
使用图像识别计数方法非常接近细胞测定方法,并且可以单独区分异常细胞。它总结了病理学家的诊断经验,最大限度地提高了计算机视觉的高速度和血细胞提取的灵活性,大大提高了工作效率,准确性和病例分析[9]。因此,开发一种能够识别红细胞并且进行计数的系统是非常重要的。
1.2国内外发展与研究现状
细胞检测计数不是一开始就很成熟的,最初的细胞识别计数方法的发展如图1.1所示。

图1.1 血液细胞检测发展流程图
现阶段细胞识别技术有如下几种:
(1)显微镜计数:将制作好的血液涂片放在显微镜下观察,进行人工计数,估算细胞数量。这样的方法计数参数很小,不能提供信息。并且由于人为误差的存在,难以保证结果的一致性。劳动力度大,不适合用于大量批次的检验。
(2)利用血球计数板计数。它是一种常见的生物学工具。计算公式为:
红细胞数/L=N×5×10×稀释倍数 (1.1)
其中N为:五个中方格的RBC总数。
在显微镜下直接观察血细胞计数板,通过观察结果来进行浓度估计。 它观察一定体积的微生物中的个体数量,然后计算其中包含的细菌数量,其简单快速。 但是,当计数时,包括以及没有活性的细胞,并且还计算微小碎片,这通常导致高结果。
(3)血液自动分析仪(Automated blood analyzer)。1947年美国的科学家库尔特(W.H.Coulter) 创造了用电阻法计数粒子的方法,1956年,他成功地将这一技术应用于血细胞计数,这种方法称为阻力法或库尔特原理[10]。到1960年,除血细胞计数外,血液分析仪还可以同时测量血红蛋白水平。1970年引入血小板计数器。1990年开发出一种能够对网织红细胞进行计数的血细胞分析仪,这使细胞识别计数又开始了一个新的历程。
细胞自动识别计数的历史开始与1950年,WallanceH.Coulte将设计出了可以用来计数细胞的专用测试仪器[10][11]。这种原理十分的简单实用,目前已经有许多国家开始生产并投入使用。从上世纪到如今,像细胞识别的仪器已经有了非常明显的进步,所以目前这样的仪器除了可以进行细胞计数之外还可以进行更多的测试,如细胞的面积大小,形状,细胞核发育以及细胞的活性度等。
关于骨髓造血功能的研究是现代医学研究的一个重要分支,而研究这个功能的重要指标就是网织红细胞计数。到现在为止,国内仍然会采用显微镜的方法。由于人工操作,它的精度仍被限制。
自动分析仪的的诞生使细胞计数技术在现实生活中已经比较成熟,但是成本略高。而且血球计数板以及显微镜观察都由人工进行,人工误差较大,不能保证数据的准确性。所以,需要一种成本不高,又具有准确性的一种计数方法,在这个时候,运用图像处理对血液细胞图片进行识别处理并计数是一种简便又高效的方法。
因此,在生物医学图像处理的算法研究依然是国内研究的热点话题。由于硬件设备的不断更新,血液涂片的制作越来越标准化,噪声不再是人们急于关注并解决的棘手问题。更重要的是细胞分割的问题。
目前,血液计数已经成为我国各级医院进行血常规检验必测的项目之一。现在,有许多的生产的细胞分析仪投入市场,但这些仪器一般功能较多且价格昂贵,并且通过一些物理特性来测定细胞个数有一定的局限性。
在国内的研究中,我国早在1960年就已经开始进行血细胞计数的研究。五年后,中国第一台血细胞计数器在上海成功制造。后来,国内的厂商跟国外的一些研究人员进行合作,生产了第二代血液分析仪。现在,国内有超过70家厂商再生产血液自动诊断仪。在医学显微镜图像处理中,图像分割一直起着重要的作用。在未来的医学研究中,计算机的应用一定会占据大量的研究资源,人工操作将会逐渐被取代。
1.3本文研究的主要内容
本文研究设计的细胞识别计数系统,主要运用图像处理的相关技术与算法实现细胞计数。具体章节安排如下:
第1章主要分析细胞识别计数的目的及意义,讨论关于细胞识别技术的发展以及研究现状。
第2章分析系统总体设计以及关键技术,阐述了系统的需求分析以及功能模块,对细胞计数方法进行初步讨论。
第3章进行细胞图像的预处理,分离空间分量,完成K均值聚类算法设计,将图像中细胞进行区域分割以及一些形态学处理。
第4章分析细胞计数技术,运用连通域算法,分水岭算法,以及面积法进行细胞计数,并分析各个算法的优缺点。在分析各个算法的同时,针对红细胞计数和白细胞计数分别选定系统中用于计数的算法。
第5章基于MATLAB平台完成细胞识别计数系统的界面设计,同时运行系统,对系统处理的结果进行分析,测试系统运行的准确度。
第6章对本次研究的工作进行总结,对本次研究的内容不断进行测试与完善,思考细胞识别系统设计及在仿真研究中存在的不足之处以及需要改进的地方,加强相关知识的学习,并对下一方向的研究做出展望。
第2章 系统总体设计和关键技术分析
在本章中,将研究系统的总体设计,阐明系统的重要性,分析系统的组成并改进系统各模块的设计理念。然后对细胞识别计数的关键技术进行分析,主要讨论血液细胞特征提取以及计数算法的相关原理。
2.1计数系统总体设计
2.1.1 需求分析
在许多研究中,有必要将不同样品之间的细胞浓度标准化,使被测试的血液有着最小的误差,并在开始实验之前测量细胞的数量。细胞计数方法有很多,最常用的细胞计数方法有采用显微镜人工计数、血球计数板计数和自动血液分析仪。
两种方法讨论如下:
(1)显微镜观察需要人工操作,而且在显微镜下观察细胞视野有限,一般用于观察细胞形态,可以观察出细胞是否正常或是否病变[12]。血球计数板同样通过人工操作,且在稀释的过程中会存在较大误差;而自动分析仪成本较高。
(2)血液自动分析仪的成本较高,不能广泛的投入使用。在已经生产的仪器中,对于细胞的评价标准没有一个非常明确的界限,并且如果有异常结果,则需要重新进行显微镜检查。
数字图像处理的产生和快速发展主要源于以下因素:计算机开发,数学发展(特别是离散数学理论的创造和改进),现实生活的需要。
图像分析方法非常直观,与细胞的判断方法非常接近,所以,需要运用图像处理的知识构建一个细胞识别系统。
2.1.2 功能模块设计
系统设计都在MATLAB软件上进行,利用MATLAB上的GUI界面设计完成计数系统的界面设计。如果选择以某种方式激活这些对象,则通常会发生操作或更改。最常见的启动方式是使用鼠标或其他鼠标指针在控制屏幕上移动。
系统首先要对读取的图像进行预处理,然后对图片中的红细胞和白细胞进行识别,最终实现细胞计数。整个系统中最关键的就是细胞识别和计数。其系统功能模块如图2.1所示。
本文要设计一个基于细胞识别计数的系统GUI界面。在MATLAB软件上完成系统的
所有设计。该系统可以实现图像输入、识别、白细胞计数以及红细胞计数的功能也能看到部分处理过程的结果。细胞计数的正确率则通过实验将实际值与计数结果进行比较得出。

图2.1 计数系统功能模块框图
2.2关键技术分析
2.2.1 血液细胞特征提取
二进制图像只有黑色和白色。一个像素只占1bit,黑色用1来表示,白色用0来表示。反过来也是一样[13]。 在亮度图像中,由于像素灰度值都由8bit表示,所以每个像素是黑色和白色之间256()种灰度中的一种。在MATLAB软件中,索引图像十分常用,最多可以显示256种颜色。首先需要定义颜色。在RGB图像中,每个像素由三个分量组成,红色、绿色和蓝色,每个分量表示0到255之间的不同的亮度值。
在本次实验中,所给的图像为彩色图像,为了分别提取出红细胞和白细胞,需要在不同的图像模型分量中选择合适的分量。提取了红细胞和白细胞后,对图像进行区域分割,然后识别出白细胞和红细胞并计数。
图像分割需要以下特征:
(1)分割区域与灰度和纹理等图像的某些属性相似。
(2)毗邻地区划分的性质明显不同。
(3)区域边界是明确的。
现有的图像分割方法只能满足部分特征,在分割区域中生成多个孔和不规则边缘很容易,突出了分割区域的相同特征约束。在计数时可能会使计数结果减少,所以在整个系统中,图像预处理部分起着十分重要的作用,会对计数结果产生重要影响。预处理完成后,就可以开始对细胞图像进行计数。
2.2.2 计数算法分析
(1)连通域标记算法
在图像中,像素是最小的单位。每个像素周围有8个连接的像素,有两种常用的邻接关系:4连接与8连接。4连接如图2.2(a)所示。8连接如图2.2(b)所示。

(a) 4连接 (b) 8连接
图2.2 中心像素的4连接、8连接
在视觉上,彼此连接的点形成一个区域,而不连接的点形成不同的区域。这样的一组互连点称为连通域。
(2)自动阈值法(Otsu法)
以上是毕业论文大纲或资料介绍,该课题完整毕业论文、开题报告、任务书、程序设计、图纸设计等资料请添加微信获取,微信号:bysjorg。
相关图片展示: